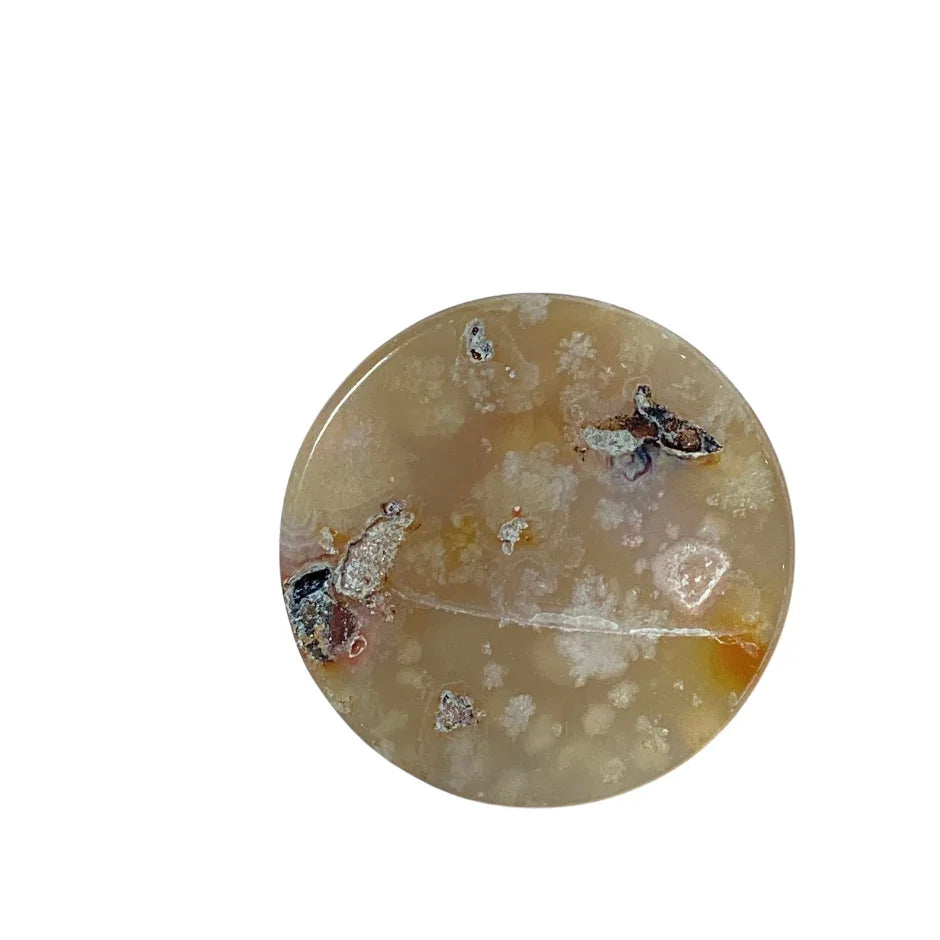
Bottom View of a Flower Agate Sphere Holder

Flower Agate Crystal Sphere Holder
Pickup currently unavailable at Body Mind & Soul
Work with flower agate stones when you want to become the most empowered version of yourself.
Crafted from the finest flower agate, this sphere holder is more than just a decoration; it's a nurturing companion on your journey to self-discovery and empowerment.
Imagine holding the universe's wisdom right in the palm of your hand. Each Flower Agate Polished sphere holder has unique delicate, flower-like formations captured within its smooth, polished surface. It's like having your own piece of a secret garden, where you discover new wonders within yourself and blossom with new growth and fresh beginnings.
Flower agate is known for its nurturing energy, encouraging you to root deeply in your own power and gently grow towards your highest potential. It's like having a wise friend by your side, reminding you of your strength and beauty, even on days when you might forget.
In a mini bowl shape, this flower agate can be used for a larger sphere holder or as a mini bowl.
Use flower agate as a daily reminder of your inner strength and the support that surrounds you. It's perfect for anyone looking to enhance their self-care routine with a touch of Earth's magic.
Details:
- Found in Madagascar
- Size: 2”D
- color: swirls of soft pink, peach, brown, rust, white
- Texture: polished
- ships fast from Houston, Texas, within 2 business days
Metaphysical properties:
- Zodiac: Gemini
- Chakra: Root and Heart
- Element: Earth
- Intentions: Growth, Joy, New Beginnings
We choose your stone(s) for you with care. Please note, this is a natural specimen and size, color, shape, and texture may vary.
Body Mind & Soul is Houston's favorite crystal shop & metaphysical store, with great offerings like Flower Agate Crystal Sphere Holder. If you have any questions about products or classes, please contact us.
Please note: Some products offered on our website are rooted in traditional and spiritual beliefs, and their benefits may not be scientifically proven, and cannot be guaranteed. For more information on the intended use and limitations of these products, please see our Disclaimer.